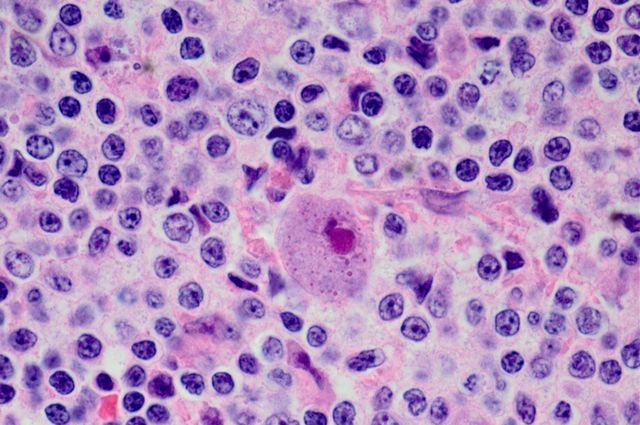
Cmvplus100x Mid

Minnie Sarwal Co-Leader of 5-year $8M NIH Grant to Study Role of CMV Infection in Kidney Transplant Rejection
UCLA, UCSF and City of Hope have received a five-year, $8 million grant from the National Institute of Allergy and Infectious Diseases to study how a common virus called cytomegalovirus may provoke the immune system to reject transplanted kidneys. Minnie M. Sarwal M.D., Ph.D., FRCP, DCH, professor and director of Precision Transplant Medicine in the UCSF Department of Surgery, is co-leader and principal investigator on the grant, which will investigate how a common virus called cytomegalovirus (CMV) may provoke the immune system to reject transplanted kidneys. Sarwal is an internationally recognized leader in renal and transplant immunology, medicine, genomics, and proteomics. The Sarwal Lab is focused on investigating the mechanisms of injury in organ failure, notably acute and chronic kidney disease, and injury in kidney transplantation.
The 14-member interdisciplinary team is co-led by principal investigator Dr. Elaine Reed, Professor of Pathology and Director of the UCLA Immunogenetics Center. It includes outstanding scientists whose specialties extend from transplant immunology and infectious disease to genomics and computational immunology, a group that includes Tara Sigdel, Ph.D. of the Sarwal Lab, transplant nephrologist Flavio Vincenti, M.D., Lewis L. Lanier, Ph.D, Professor and Chair of the Department of Microbiology and Immunology, UCSF and Marina Sirota, Ph.D, Assistant Professor at the Institute for Computational Health Sciences at UCSF. In 2016, there were 33,611 transplants performed in the U.S., nearly 60% for kidneys. An estimated 15 percent of kidney transplant patients develop CMV infections following surgery, which are one of the leading causes of organ failure and death. Sarwal believes the grant will be critical in helping to gain a better understanding of CMV infection in transplant patients, thus enabling early detection strategies and effective treatments to be developed.
Cytomegalovirus or CMV is a virus that infects nearly 70% of adults worldwide with little impact. However, in transplant patients taking powerful immunosuppressive medications, the CMV virus can wreak havoc, making the patients very ill. The virus can often be difficult to detect and treat quickly. With the support of the grant, we hope to better understand how to detect, prevent and treat CMV infection in organ transplant recipients and other immunocompromised patients to significantly improve their quality of life and the function of their transplanted organs.
The consortium will study two types of immune responses in kidney transplant patients with CMV. The first, innate immune response, is a general inflammatory reaction, i.e., inflammation, the first line of defense against infections, which clears disease-causing agents from the immune system. Innate responses trigger a secondary response, the adaptive immune response, a delayed reaction to a specific stimulus. Adaptive immunity is important because antibodies to the virus provide long-lasting protection against it. The project will endeavor to create a molecular map of the cross-talk between the patient’s innate and adaptive immune responses.
Another research goal is the development of effective vaccines against CMV. By profiling the immune systems of transplant recipients who successfully ward off CMV infection and comparing them with patients who suffer persistent infection, the group hopes to identify high-risk patients who will need closer monitoring and specific interventions against CMV.
Overview and Selected Projects
Mapping Immune Responses to CMV in Renal Transplant Recipients (NIH RePORTER)
Summary/Abstract
Cytomegalovirus (CMV), a member of the Herpes virus family, has evolved alongside humans for thousands of years with a complex balance of latency, immune evasion, and transmission. While up to 70% of humans worldwide have evidence of CMV infection and seroprevalence approaches 100% in certain areas, healthy people show little to no clinical symptoms of primary infection. CMV disease is rarely observed in immune competent hosts because of innate immune responses and constant surveillance by natural killer (NK) and T cells that cooperatively control CMV. However, CMV is one of the most problematic pathogens in the immunocompromised host, after solid organ and stem cell transplantation causing increased risk of graft dysfunction, mortality and graft loss.
We propose to study the innate and adaptive immune responses to CMV in immunocompromised solid organ transplant recipients using a high-throughput systems biology approach, carefully curated clinical phenotypes and novel statistical and computational approaches to: a) profile innate and adaptive immune responses during primary CMV infection and define the effects of CMV infection on the development of alloimmune responsiveness and transplant rejection; b) determine the role of NK cells in CMV reactivation and chronic transplant rejection and c) define the effects of CMV infection on the development of chronic allograft injury. The long-term goal of the proposed research is to develop a detailed molecular map of the cross-talk between the innate and adaptive immune response in primary and latent CMV infection in the transplant recipient. Detailed insights into the interaction of the virus with the immune system stand to generate concepts for more adequate vaccine strategies, risk assessment for CMV infection to better understand the immune system and to define the interplay of CMV infection and organ transplant injury.
Public Health Relevance Statement
Mapping Immune Reponses to CMV in Renal Transplant Recipients NARRATIVE Cytomegalovirus (CMV) is a ubiquitous, genetically stable herpes virus that infects approximately 70% of the human population and establishes lifelong persistence. Primary infections as well as latency normally occur asymptomatically in immunocompetent hosts. However, in immunocompromised persons, such as transplant recipients, coexistence of CMV with the host leads to viral reactivation and disease associated with high morbidity and mortality. Furthermore, chronic CMV infection accelerates senescence of the immune system with a resultant high level of chronic subclinical inflammation which drives transplant morbidity and loss. We will use high-throughput systems biology technologies and novel statistical and computational approaches to characterize the innate and adaptive immune response to CMV in the setting of solid organ transplantation. Understanding the components of the immune response to CMV will provide valuable insights into chronic rejection and identify new approaches to guide patient management and therapy.
PROJECT 3: Mapping the Evolution of Chronic Transplant Injury in the Context of CMV Infection
Project Leader - Minnie M. Sarwal M.D., Ph.D., FRCP, DCH
SUMMARY/ABSTRACT CMV infection drives inflammation in the context of organ transplantation, and is associated with chronic rejection in the allograft, which drives accelerated allograft loss and transplant failure. The cascade of molecular mechanisms that trigger graft inflammation in the context of CMV infection are poorly understood. Whole genome, proteome, and immunome profiling of CMV infection and disease in the context of organ transplantation can generate a comprehensive global database to understand CMV infection and reactivation in an immunocompromised host and help design novel strategies to prevent viral reactivation and dampen anti- donor immunity.
In Project 3, we propose to study the evolution of immune responses that drive acute rejection, chronic rejection, and CMV virus infection in kidney transplant recipients by serial assessments of graft transcriptional perturbations (Aim 1), clonal expansion of peripheral T cell and B cell receptors (TCRs and BCRs) through next gene expression sequencing (NGS), and variations in humoral responses to reactivation of antigenic epitopes by high-throughput antibody profiling (Aim 2). In addition, we propose to generate biomarkers for non-invasive monitoring of chronic graft injury by measuring changes in donor derived cell free DNA (dd-cfDNA) by massively multiplexed PCR (mmPCR) and highly refined gene-sets (kSORT and uCRM) mined from previous high-throughput microarray studies (Aim 3). We propose to use a cohort of kidney transplant patients from two of the largest multi-organ transplant programs in the US (UCSF and UCLA).